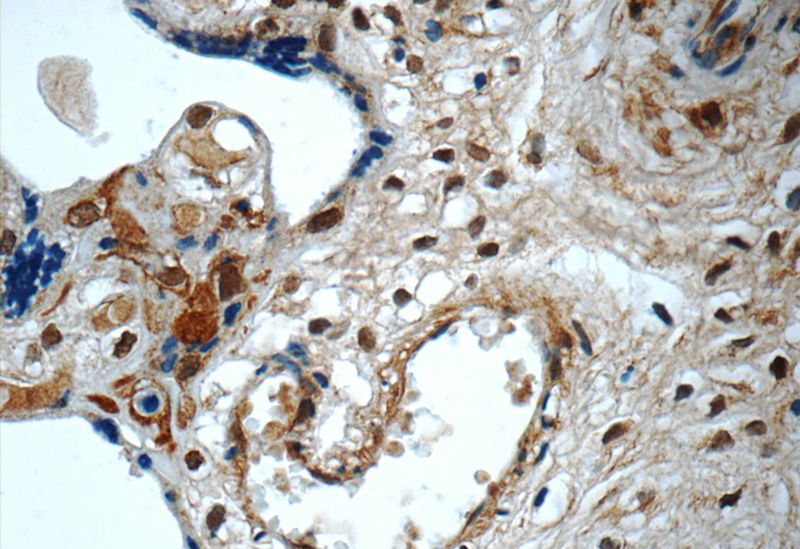
Immunohistochemistry of paraffin-embedded human placenta tissue slide using Catalog No:115418(SMAD4 Antibody) at dilution of 1:50 (under 40x lens)
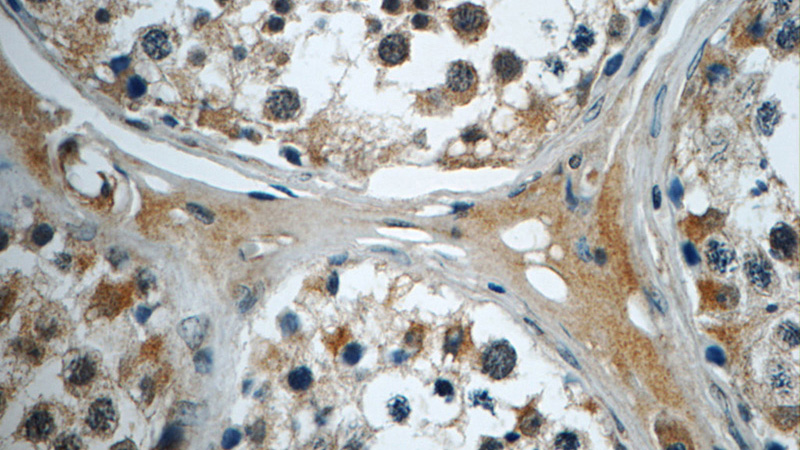
Immunohistochemistry of paraffin-embedded human testis tissue slide using Catalog No:115418(SMAD4 Antibody) at dilution of 1:50 (under 40x lens)

-
Product Name
SMAD4 antibody
- Documents
-
Description
SMAD4 Rabbit Polyclonal antibody. Positive IP detected in mouse liver tissue. Positive WB detected in HEK-293 cells, A549 cells, HepG2 cells, MCF7 cells, mouse liver tissue, NIH/3T3 cells, SMMC-7721 cells. Positive IHC detected in human placenta tissue, human testis tissue. Observed molecular weight by Western-blot: 63-70 kDa
-
Tested applications
ELISA, WB, IHC, IP
-
Species reactivity
Human, Mouse; other species not tested.
-
Alternative names
DPC4 antibody; hSMAD4 antibody; JIP antibody; MAD homolog 4 antibody; MADH4 antibody; Mothers against DPP homolog 4 antibody; SMAD 4 antibody; SMAD family member 4 antibody; SMAD4 antibody
-
Isotype
Rabbit IgG
-
Preparation
This antibody was obtained by immunization of SMAD4 recombinant protein (Accession Number: NM_001407042). Purification method: Antigen affinity purified.
-
Clonality
Polyclonal
-
Formulation
PBS with 0.1% sodium azide and 50% glycerol pH 7.3.
-
Storage instructions
Store at -20℃. DO NOT ALIQUOT
-
Applications
Recommended Dilution:
WB: 1:200-1:2000
IP: 1:200-1:2000
IHC: 1:20-1:200
-
Validations

HEK-293 cells were subjected to SDS PAGE followed by western blot with Catalog No:115418(SMAD4 antibody) at dilution of 1:600

IP Result of anti-SMAD4 (IP:Catalog No:115418, 4ug; Detection:Catalog No:115418 1:600) with mouse liver tissue lysate 4000ug.
Immunohistochemistry of paraffin-embedded human placenta tissue slide using Catalog No:115418(SMAD4 Antibody) at dilution of 1:50 (under 40x lens)
Immunohistochemistry of paraffin-embedded human testis tissue slide using Catalog No:115418(SMAD4 Antibody) at dilution of 1:50 (under 40x lens)
-
Background
Mammalian homologs of the Drosophila Mad gene include Smad1, Smad2, Smad3, Smad4 (DPC4), Smad5, Smad6, Smad7 and Smad8. Smad1 and Smad5 are effectors of BMP2 and BMP4 function while Smad2 and Smad3 are involved in TGF and activin-mediated growth modulation. Smad4 has been shown to mediate all of the above activities through interaction with various Smad family members . Smad6 and Smad7 regulate the response to activin/ TGF signaling by interfering with TGF -mediated phosphorylation of other Smad family members. This antibody is a rabbit polyclonal antibody raised against an internal region of human SMAD4.
-
References
- Du J, Wang J, Tan G. Aberrant elevated microRNA-146a in dendritic cells (DC) induced by human pancreatic cancer cell line BxPC-3-conditioned medium inhibits DC maturation and activation. Medical oncology (Northwood, London, England). 29(4):2814-23. 2012.
- Javle M, Li Y, Tan D. Biomarkers of TGF-β signaling pathway and prognosis of pancreatic cancer. PloS one. 9(1):e85942. 2014.
- Chen MS, Zhang JH, Wang JL, Gao L, Chen XX, Xiao JH. Anti-fibrotic effects of neferine on carbon tetrachloride-induced hepatic fibrosis in mice. The American journal of Chinese medicine. 43(2):231-40. 2015.
Related Products / Services
Please note: All products are "FOR RESEARCH USE ONLY AND ARE NOT INTENDED FOR DIAGNOSTIC OR THERAPEUTIC USE"
